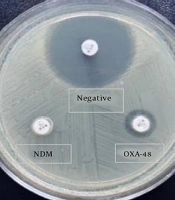
Jundishapur J Microbiol

1. Background
Multiple antibiotic resistance is currently defined as one of the top 10 global public health threats facing humanity, necessitating urgent measures (1). Carbapenem resistance develops as a result of the intensive or inappropriate use of carbapenems as last-line therapeutic agents, especially in the treatment of bacterial infections, producing extended-spectrum beta-lactamase (ESBL) and AmpC beta-lactamase. The issue has escalated in significance, emerging as the leading cause of hospital-acquired infections associated with high morbidity and mortality (2, 3).
Antibiotics available for treating infections caused by carbapenemase-producing microorganisms are limited, with newly developed options (4). Therefore, when there is a decrease in carbapenem susceptibility in routine antibiotic susceptibility tests, it is important to rapidly confirm whether the microorganism produces carbapenemase by phenotypic and/or genotypic methods. This is necessary to take necessary infection control measures to prevent the spread of carbapenemase-producing microorganisms and effectively use these antibiotics in treatment (5).
Genotypic analyses are considered the gold standard for detecting carbapenemase genes, but molecular methods remain costly, time-consuming, and limited to the targets used in the test. Therefore, there is a need for simpler phenotype-based analyses for carbapenemase screening in clinical microbiology laboratories (6). Currently, various phenotypic methods are used for in vitro carbapenemase detection, including growth-based analyses (such as selective chromogenic media and inhibitor-based combination disk tests), multiplex immunochromatographic lateral flow methods, colorimetric biochemical methods (Carba NP, Blue-Carba, β-CARBA), carbapenem inactivation methods (CIM, mCIM, eCIM, mCIMplus, sCIM, rsCDM), immunological tests (RESIST-3 O.K.N. and NG-Test CARBA 5), and carbapenem hydrolysis analysis by MALDI-TOF MS (7-13).
While these tests exhibit varying sensitivities in detecting different carbapenemases, some are time-consuming (requiring at least 12 - 24 hours) and expensive, others can only detect certain carbapenemases, some necessitate experience to apply and evaluate the results, and some require additional material for analysis (e.g., EDTA, boronic acid, etc.). For this reason, they may only be partially suitable for the rapid detection of carbapenemases in microbiology laboratories to prevent hospital-acquired epidemics (9-13). In 2019, Jing et al. described the rapid carbapenemase detection method (rCDM) as a new phenotypic method based on carbapenem inactivation with high sensitivity and specificity, which is easy to implement and interpret, allowing rapid results for detecting the presence of carbapenemases (14).
2. Objectives
The aim of this study was to evaluate the sensitivity of the newly developed rCDM using isolates whose resistance genes were determined by molecular methods and to compare it with the modified carbapenem inactivation method (mCIM), whose diagnostic performance characteristics are well-defined and recommended by the Clinical and Laboratory Standards Institute (CLSI)
3. Methods
3.1. Bacterial Isolates
A total of 130 Klebsiella pneumoniae isolates [65 carbapenem-resistant (CR) and 65 carbapenem-sensitive (CS)] were included in the study. These isolates were obtained from various clinical samples sent to the clinical microbiology laboratory of Bakırköy Sadi Konuk Training and Research Hospital were included in the study. The majority of the isolates were obtained from urine specimens (62, 47.7%), followed by respiratory specimens (21, 16.2%), wound and soft tissue specimens (20, 15.4%), blood (19, 14.6%), and others (8, 6.1%). Identification and antibiotic susceptibility testing of the isolates were performed using the BD Phoenix™ automated system (BD Diagnostic Systems, Sparks, MD, USA) according to CLSI recommendations (15). Carbapenem resistance was confirmed by gradient testing (Oxoid, Thermo Fisher Scientific, Cambridge, UK) when resistance to at least one of the carbapenems (imipenem, meropenem, and ertapenem) was detected. Klebsiella pneumoniae ATCC 1705 and 1706 were used as CR and CS control isolates for quality control of phenotypic tests.
3.2. Detection of Carbapenemase Genes
Carbapenem resistance genes of the 65 carbapenem-resistant K. pneumoniae (CRKP) isolates (51 oxacillinase-48 (OXA-48), 12 NDM-1, 1 OXA-48+NDM-1, and 1 VIM-5) included in the study were previously detected by a molecular method (PCR) (16).
3.3. Rapid Carbapenemase Detection Method (rCDM)
The method optimized by Jing et al. in 2019 was used (14). Briefly, mueller hinton Agar (MHA) (Oxoid, Thermo Fischer Scientific, Cambridge, UK) was used to prepare the 3 mm thickness MHA medium used in the rCDM test. Escherichia coli ATCC 25922 bacterial suspension prepared at 3.0 McFarland density was spread on a 3 mm thickness MHA medium according to the standard disk diffusion procedure. The media were allowed to stand for 3 - 10 minutes. Then, 1 - 3 colonies obtained from fresh passages of the isolates to be tested were spread as a thin layer on the surface of a 10 µg imipenem disk (Oxoid Ltd., Basingstoke, UK), and then the bacteria-containing side of the disk was immediately placed on MHA medium.
Four disks were placed on a plate, with the imipenem disks containing the three isolates to be tested and an imipenem disk without bacterial spread as a control. After incubation at 35 ± 2°C for 5 and 6 hours, inhibition zones were evaluated by two different people, and inhibition zone diameters were recorded. The test isolates underwent rCDM testing, which was repeated twice. The test was considered carbapenemase-positive if the zone diameter difference between the tested isolate and the control was ≥ 5 mm and carbapenemase-negative if the difference was < 3 mm. Results falling between 3 - 5 mm were considered indeterminate, and the test was repeated (Figure 1).
Rapid carbapenemase detection method (rCDM) results (6h). Control the imipenem disk inhibition zone at a 24 mm diameter (upper left corner). The inhibition zone diameter of the carbapenem-sensitive Klebsiella pneumoniae isolate is 23 mm. (upper right corner). The diameter of rCDM-positive isolates producing NDM and oxacillinase-48 (OXA-48) were 6 mm and 14 mm, respectively (below left and below right corners).
3.4. Modified Carbapenemase Inactivation Method (mCIM-CLSI)
The mCIM was performed and interpreted according to the CLSI recommendations for 2021 (Figure 2) (17).
Modified carbapenemase inactivation method results (18h). Carbapenem-sensitive Klebsiella pneumoniae isolate inhibition zone was 23 mm (upper isolate). The inhibition zone diameter of NDM producing isolate (below left corner) and the oxacillinase-48 (OXA-48) producing isolate (below right corner) were 6 and 8 mm respectively.
3.5. Statistical Analysis
McNemar’s test was used to examine the difference in the test results between rCDM, mCIM, and PCR. Additionally, Kappa coefficients were provided to indicate the degree of consistency. Data analysis was performed using SPSS 22.0. (18), with P < 0.05 considered statistically significant.
4. Results
When the distribution of resistance genes of the 65 CRKP isolates included in the study was evaluated, blaOXA-48 was detected most frequently in 78% (51/65), followed by blaNDM-1 in 18% (12/65). While blaOXA-48+NDM-1 and blaVIM were each detected in 2% (1/65) of isolates, other resistance genes were not detected. The mCIM and rCDM results for a total of 130 K. pneumoniae isolates are shown in Table 1, with the advantages and disadvantages of both phenotypic methods summarized in Table 2.
| Klebsiella pneumoniae (n = 130) | rCDM (6 h) | mCIM (18 h) | |||
|---|---|---|---|---|---|
| Positive | Negative | Zone Diameter (mm) | Positive | Negative | |
| Carbapenem-resistant (n = 65) | |||||
| OXA-48 51 (78) | 51 | 0 | 6 - 16 | 51 | 0 |
| NDM-1 12 (18) | 12 | 0 | 6 - 9 | 12 | 0 |
| OXA-48+ NDM-1 1 (2) | 1 | 0 | 6 | 1 | 0 |
| VIM-5 1 (2) | 1 | 0 | 12 | 1 | 0 |
| Carbapenem-sensitive (n = 65) | |||||
| NT | 0 | 65 | 22 - 25 | 0 | 65 |
Abbreviations: NT, not tested; mCIM, modified carbapenem inactivation method; rCDM, rapid carbapenemase detection method; OXA-48,oxacillinase-48.
| Test Parameter | Accuracy Regulatory Status | Ease of Use Testing Requirements | Require Initial Setup | Total Time to Perform Test | Turnaround Time (h) | Total Cost | Interpretation of Results (Zone Diameter) |
|---|---|---|---|---|---|---|---|
| Modified carbapenem inactivation method | Sensitivity 97% specificity 99% CLSI laboratory developed tested. | Easy to perform No special reagent meropenem disk | Incubation of meropenem disk for 4 h with tested isolates | 5 min for initial setup 10 min to inoculated plate 2 min to read the following day | 18 - 24 | Very low | ≥ 19 mm negative 16 - 18 mm indeterminate ≤ 15 mm. positive |
| Rapid carbapenemase detection method | Sensitivity 100% specificity 99.6% laboratory developed and tested. | Easy to perform 3 mm. MHA plates imipenem disk | None | 5 min for initial setup 10 min to inoculated plate 2 min to read the same day | 5 - 6 | Very low | Difference ≥ 5 mm positive 3 - 5 mm indeterminate ≤ 3 mm. negative |
4.1. Rapid Carbapenemase Detection Method Results
The inhibition zone diameters of 65 CS isolates, which tested negative with rCDM, ranged between 22 and 25 mm (Table 1 and Figure 3). In contrast, all 65 CRKP isolates known to possess carbapenemase genes tested positive with rCDM (Table 1). The inhibition zone diameters of these isolates were 6 mm, except for 18 isolates. Of these, 16 were positive for OXA-48, 1 for NDM-1, and 1 for VIM-5, with zone diameters of 9 - 16 mm, 9 mm, and 12 mm, respectively (Table 1 and Figure 3). The zone diameters of the control imipenem disks ranged between 21 and 25 mm. In cases where test results were indeterminate, rCDM was repeated for 2 OXA-48 and 5 CSKP isolates without encountering any issues. The inhibition zone diameters of the isolates studied with rCDM were measured twice, at the 5th and 6th hours. Although there was no significant difference between the two measurements, it was found that the measurement and interpretation were easier because bacterial growth was better at the 6th hour.
4.2. Modified Carbapenem Inactivation Method Results
Inhibition zone diameters of all 65 CS K. pneumoniae isolates, testing negative with the mCIM, were > 19 mm., ranging between 22 and 27 mm (Figure 3). Conversely, all 65 CR K. pneumoniae isolates, known to harbor carbapenemase genes, tested positive with mCIM (Table 1). The inhibition zone diameters of these isolates were 6 mm, except for four isolates, all of which were positive for OXA-48, with inhibition zone diameters ranging between 8 - 10 mm (Figure 3). No CS and CR isolates required retesting with the mCIM.
4.3. Statistical Results
When polymerase chain reaction results were accepted as the gold standard method for carbapenemase detection, the sensitivity of the rCDM was found to be 100% for readings at both the 5th and 6th hours. However, the specificity of the rCDM could not be calculated since the presence of carbapenemase genes was not investigated by PCR in the CS control group. For CR and CS K. pneumoniae isolates, no statistically significant difference was found between rCDM and mCIM (PMc Nemar =1, Kappa = 1.00). The test results for a total of 130 K. pneumoniae isolates indicated a 100% concordance rate between phenotypic rCDM and mCIM tests, demonstrating complete consistency.
5. Discussion
Carbapenem-resistant K. pneumoniae is one of the nosocomial pathogens that can cause outbreaks with high mortality rates, particularly among intensive care patients (2). The prevalence of CRKP infections is increasing and exceeds 50% in some parts of Europe and the Eastern Mediterranean (19). The most common resistance mechanism in CRKP is carbapenemase enzyme production, which is usually encoded by plasmids and can easily and rapidly spread among other microorganisms (3). Therefore, awareness of the prevalence and incidence of local carbapenemase genotypes is crucial for appropriate treatment selection and prevention of their spread.
Today, its prevalence varies according to geographical regions; K. pneumoniae carbapenemases (KPCs), New Delhi metallo-beta-lactamase (NDM), and OXA-48 are the three most frequently reported carbapenemases worldwide (20, 21). OXA-48-producing K. pneumoniae was first isolated in Istanbul in 2001 (22) and since then has remained the predominant carbapenemase type in Türkiye and most of Europe (23). In our country, NDM-1 is the second most common carbapenemase, particularly among K.pneumoniae isolates. Studies have reported that the Balkan countries and the Middle East as secondary reservoirs of NDM-1 (24). Other carbapenemase types (KPC, VIM, IMP, etc.) and co-productions, often OXA-48 and NDM-1, are sporadically observed (16, 25, 26). In accordance with the literature, 78% of the CRKP isolates included in our study tested positive for the OXA-48 (n = 51), for the 18% NDM-1 (n = 12), and 2% for the VIM-5 (n = 1) genes positive. Oxacillinase-48 and NDM-1 gene co-production was detected in one isolate. IMP and KPC genes were not detected.
To prevent the spread of carbapenemase-producing microorganisms, guidelines recommend timely detection of isolates (17, 27, 28). Rapid and accurate detection of carbapenemases by cost-effective methods with high sensitivity and specificity is critical for patient management, especially in critically ill patients when reduced carbapenem susceptibility is detected. Beyond the diagnostic performance of the test, it is important to consider several factors, such as labor intensity, cost, turnaround time, equipment, and material requirements, when selecting the most appropriate test for the differentiation of CS and CR isolates (11).
Currently, none of the tests recommended by CLSI (17) and EUCAST (European Committee on Antimicrobial Susceptibility Testing) (27) for the detection of carbapenem resistance, whether phenotypic or genotypic, are ideal for detecting all carbapenemase genes. Studies have demonstrated their different advantages and disadvantages (9-13, 29). In 2017, CLSI recommended mCIM, a simple, easy-to-use, and inexpensive test for the detection of carbapenemases. Studies have reported that carbapenemases, including OXA-48 and NDM, commonly found in K. pneumoniae, can be detected with 97 - 100% sensitivity and specificity (9-11, 29, 30). In our study, all CR isolates were found to be positive at the 18th hour mCIM evaluation, with a sensitivity of 100%. All CS isolates were negative by mCIM, and no isolates needed to be retested.
The mCIM is easy to interpret. However, the fact that the test requires a 4-hour pre-incubation can be a disadvantage for laboratories as it increases the workload. More importantly, it requires overnight incubation and cannot yield results on the same day. Recently, Jing et al. described rCDM (14), a simple method with high sensitivity and specificity that can be implemented at low cost in any laboratory and can detect carbapenemases within 5 - 6 hours. In rCDM, no pretreatment is needed because the bacteria to be tested are smeared directly onto the surface of the imipenem disk. In their study, which included a total of 200 Enterobacterales isolates producing KPC-2, IMP-4, NDM-1, VIM-1, IMP-2, and OXA-48, all isolates tested positive using the rCDM method. Of the 57 non-carbapenemase isolates, only one K. pneumoniae with CTX-M-15 isolates was false positive with rCDM.
The authors reported sensitivity and specificity as 100% and 99.6%, respectively. In another study by Çalık et al. (31), which included 92 isolates, mostly OXA-48 and OXA-48+NDM co-production, the sensitivity of the rCDM was 100% when the PCR method was accepted as the gold standard. In fact, it has been reported that OXA-48 producers, which are endemic in our country, do not have inhibitors such as metal chelators that can be used in its detection and also show low-level resistance to carbapenems, making them easily overlooked in routine susceptibility testing and phenotypic carbapenem resistance detection methods (24, 29). In our study, similar to other rCDM studies, all CRKP isolates were found positive by rCDM, and the sensitivity was 100%. All CS isolates were found negative by rCDM. Tests were repeated on seven isolates, two CR (OXA-48) and five CS, whose test results were considered indeterminate, with no problems observed during the repetition. This may be because rCDM results can be affected by the amount of bacteria coated on the imipenem disk. The test may be negative if the imipenem disk is not covered with an adequate amount of bacteria, but it may also be "indeterminate or positive" if it is smeared with a dense bacterial inoculum, especially in CTX-M-like ESBL-producing isolates. In our study, rCDM results for K. pneumoniae isolates were 100% compatible with mCIM and showed excellent reproducibility. The results of our study show that rCDM is a very practical choice, especially in regions where OXA-48 is endemic, and CRKP infections are common.
The method offers high sensitivity and specificity, is cost-effective, easy to perform, and requires readily available material. Furthermore, interpreting the results is easier than many other phenotypic tests due to its reliance on measuring the inhibition zone diameter. However, our study had some limitations. It only included isolates associated with a limited range of carbapenemase genes common in our region and solely focused on K. pneumoniae isolates. Therefore, new studies are required to evaluate the performance of the rCDM across different carbapenemase types and carbapenem-resistant microorganisms.
One major advantage of rCDM over mCIM is the ability to obtain results on the same day, typically in a short time frame of 5 - 6 hours. In a study investigating carbapenemase detection at the 6th hour with mCIM, it was reported that while CR isolates could be detected, there was difficulty in detecting CS isolates due to poor growth at 6 hours (30). Because a more concentrated E. coli inoculum was used in rCDM, evaluation was easier due to better growth at 6 hours compared to mCIM. It is recommended to use 3 mm thick MHA plates in rCDM, which may pose a slight disadvantage for the test. Typically, 4 mm. MHA plates are used in routine antibiotic susceptibility testing, making them more commercially available. Conversely, 3 mm MHA plates are less commonly used, resulting in limited commercial availability. However, laboratories can easily make their own MHA plates and can request commercial media for rCDM, although availability may be limited.
5.1. Conclusions
Rapid and reliable detection of carbapenemase production facilitates prompt therapeutic decision-making and infection control measures. The rCDMs is a highly sensitive and rapid, easy-to-perform, cost-effective, and simple-to-interpret method, which requires only basic laboratory equipment. This test can be easily adapted in all clinical laboratories with limited resources for early detection of carbapenemases, especially in populations where OXA-48 and NDM carbapenemases are common.